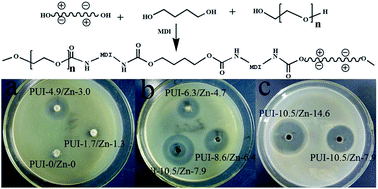
Graphical abstract: Synthesis and characterization of a polyurethane ionene/zinc chloride complex with antibacterial properties

The 1,6-bis(N′,N-dimethyl-3-hydroxylpropyl) ammonium chloride (BQAC–diol)/zinc chloride complex was first synthesized and used as an ionic monomer to synthesize a polyurethane ionene/zinc chloride (PUI/ZnCl2) complex via its polymerization with poly(ethylene glycol) (PEG), 1,4-butanediol (BDO), and 4,4′-diphenylmethane diisocyanate (MDI). The structure and properties of the PUI/ZnCl2 complex were characterized systematically by NMR, intrinsic viscosity, thermogravimetric analysis (TGA), differential scanning calorimetry (DSC), polarized optical microscopy (POM), and tensile testing, and the antibacterial properties were investigated using a cylinder-plate method. The results indicated that the crystallization rate of PUI/ZnCl2 increased gradually with increasing content of ionic units, which was ascribed to the increased crystal growth rate as evidenced by POM observation. The morphology analyzed by scanning electron microscopy indicated that no apparent microphase separation occurred for the complex and ZnCl2 dispersed at a molecular level in the PUI matrix, since no particle-like species can be observed. Antibacterial properties measurement showed that the PUI containing quaternary ammonium salt cation has no antibacterial activity but the coexistence of ZnCl2 and cation exhibit a synergetic effect with respect to the antibacterial activity.